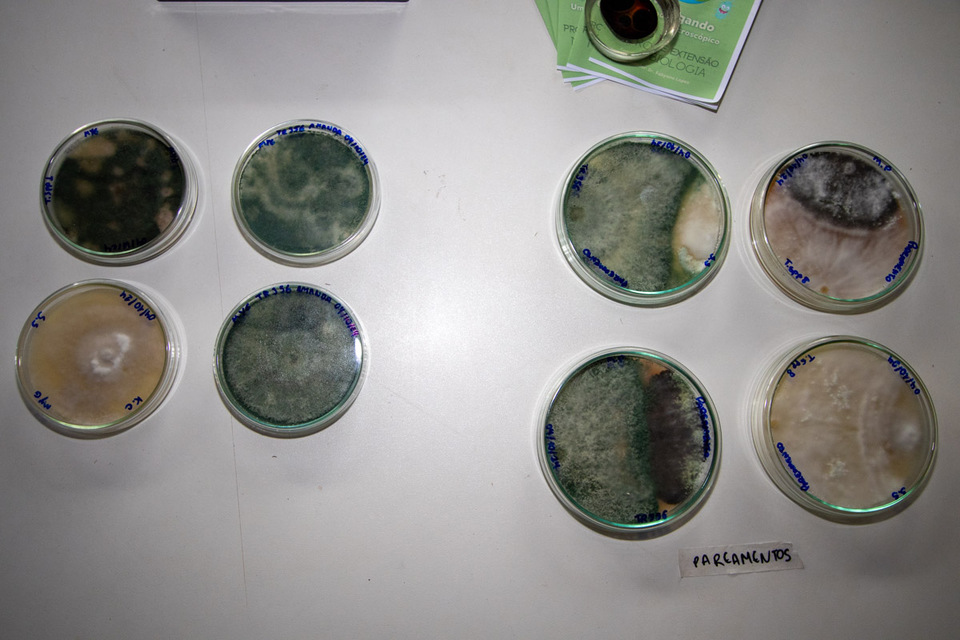
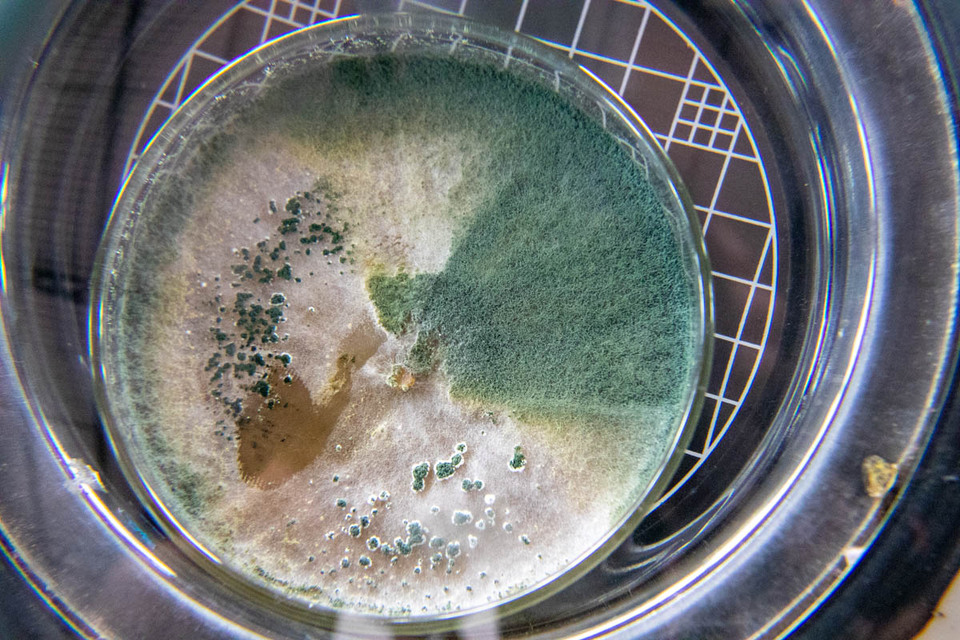

Esse site utiliza cookies
Projeto da UFT leva conhecimento sobre biologia para estudantes de escolas de Novo Acordo
Com foco na preservação e valorização do Cerrado tocantinense, o projeto “Insetos do cerrado tocantinense: conhecer para preservar”, coordenado pelo professor Tiago Krolow, do curso de Ciências Biológicas no Câmpus de Porto Nacional, visitou, no dia 16 de outubro, o Colégio Estadual Professora Eliacena Moura Leitão, em Novo Acordo. A ação integra a 21ª Semana Nacional de Ciência e Tecnologia (SNCT), com o tema “Biomas do Brasil: diversidade, saberes e tecnologias sociais”, e contou com a participação de aproximadamente 450 estudantes de outras duas escolas: a Escola Estadual Pedro Macedo e a Escola Municipal Ruidelmar Limeira Borges.
O professor Tiago Krolow destacou que o projeto foi ampliado para incluir uma abordagem mais integrada: “Quando submeti o projeto ao edital do CNPQ, eu enviei uma proposta individual do laboratório, mas ao ser contemplado, percebi que poderia ampliar e convidar colegas para participar. Assim, conseguimos desenvolver uma atividade ainda mais completa e interessante para quem participou”.
Além das oficinas, pensadas para atender estudantes de diferentes faixas etárias, o projeto também envolve visitas de escolas à UFT, no Câmpus de Porto Nacional, oferecendo aos jovens uma oportunidade de vivenciar o ambiente acadêmico. “A proposta da SNCT é levar a universidade para fora dos seus muros, mas também trazer os estudantes para dentro dela. Vamos receber quatro colégios, de diferentes municípios, para que os estudantes conheçam o Câmpus e a rotina acadêmica”, explicou Krolow.
Inspiração para os alunos
O evento foi também uma oportunidade de destacar o papel da ciência na vida dos jovens. O professor de Ciências e Biologia do Colégio Estadual Professora Eliacena Moura Leitão, Alexandre Cordeiro, comemorou a parceria com a UFT e reforçou a importância de popularizar o conhecimento científico: “A gente tenta incentivar os estudantes a criarem uma expectativa, a terem mais interesse pela universidade. Com a precarização do incentivo à ciência, esse tipo de evento faz com que a comunidade enxergue a universidade como algo próximo e acessível, despertando o desejo de ingressar no ensino superior, seja na Biologia ou em outras áreas”.
Alexandre coordena o projeto Semaforontes na escola, que busca aproximar os alunos da Biologia e da prática científica: “O projeto nasceu da minha vontade de trazer os estudantes mais para a prática da biologia e, com isso, tentar despertar vocações. O nome Semaforonte remete ao estágio de desenvolvimento de uma espécie, e a ideia é que o estudante se veja em uma fase de metamorfose, como no nosso logo, onde uma pessoa sai de um casulo e cria asas”.
Exemplos que motivam
Um dos momentos mais emocionantes do evento foi a exibição de um vídeo enviado pela ex-aluna da escola de Novo Acordo, Lia Pereira Oliveira, e egressa do curso de Biologia da UFT, que agora está no doutorado na Universidade Federal do Amazonas (Ufam). A ex-aluna compartilhou sua trajetória, agradeceu aos professores e buscou motivar os estudantes a seguirem seus sonhos acadêmicos. A professora de Inglês, Vânia Soares de Amorim, citada no vídeo, falou sobre o orgulho de ver a ex-aluna prosperar: “Ver que a Lia, fruto da nossa escola, foi para a UFT e agora faz doutorado nos enche de orgulho. Ela é um exemplo de que, com determinação, é possível realizar sonhos, mesmo vindo de uma origem simples”.
A estudante Sabrina Novais, de 16 anos, participante do projeto Semaforontes, também destacou o impacto do evento: “Participar desse projeto está sendo muito interessante. A gente aprende muito, desde a pesquisa até a coleta, e isso me deixou curiosa para saber mais sobre várias áreas, como botânica, animais e insetos. Nosso objetivo é catalogar a fauna e flora da região, e isso tem sido uma experiência enriquecedora”.
Extensão e pesquisa para a comunidade
O diretor de Pesquisa da UFT e professor do curso de Biologia, Thiago Nilton Alves Pereira, também esteve presente no evento e ressaltou a importância de iniciativas como essa: “Essas atividades de extensão são fundamentais para aproximar a universidade da sociedade. Por muito tempo, a ciência foi vista apenas dentro dos seus próprios pares, mas, recentemente, a extensão tem despontado como uma forma de mostrar a importância da universidade para a comunidade. São essas atividades que ajudam a fomentar a pesquisa, a extensão e o ensino, mostrando o impacto que a universidade pode ter”.
O projeto “Insetos do cerrado tocantinense: conhecer para preservar” segue desenvolvendo ações tanto nas escolas quanto no Câmpus de Porto Nacional, reforçando a importância da ciência e da universidade na construção de um futuro mais sustentável e conectado com as comunidades do interior.